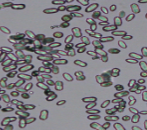
<p>What is this?</p>

1/40
Looks like no tags are added yet.
Name | Mastery | Learn | Test | Matching | Spaced | Call with Kai |
|---|
No analytics yet
Send a link to your students to track their progress

What is this?
Cholesterol Crystal (pink)

What is this?
Cholesterol Crystal (black)

What is this?
Triple Phosphate Crystal (gray)

What is this?
Triple Phosphate Crystal (blue)

What is this?
Ammonium biurate Crystal

What is this?
Uric Acid Crystal

What is this?
Calcium Oxalate dihydride
What is this?
Calcium Oxalate Monohydrate (gray)

What is this?
Calcium Oxalate Monohydrate (hourglass)

What is this?
Leucine Crystal (metabolic disorder)

What is this?
Tyrosine Crystal (metabolic disorder)

What is this?
Cystine crystal

What is this?
Starch crystal (gray)

What is this?
Starch crystal (yellow)

What is this?
RBC Cast

What is this?
Granular cast (yellow)

What is this?
Granular cast (gray)

What is this?
WBC Cast (2arrows)

What is this?
WBC Cast (4arrows)

What is this?
Epithelial Cast

What is this?
Hyaline Cast (green)

What is this?
Hyaline Cast (blue)

What is this?
Fatty Cast

What is this?
Broad Cast

What is this?
Waxy Cast

What is this?
Fiber (Artifact)

What is this?
Red Blood Cell

What is this?
Epithelial Cells

What is this?
Transitional epithelial cells

What is this?
Clue cell

What is this?
White blood cell

What is this?
Bacteria

What is this?
Budding Yeast (gray)

What is this?
Budding Yeast (white)

What is this?
Hyphae yeast

What is this?
Sperm

What is this?
Mucous

What is this?
Fat drops

What is this?
Ampicillin

What is this?
Sulfonamide

What is this?
Trichomonas